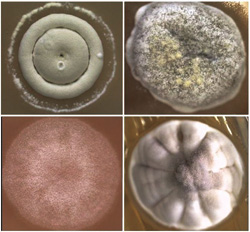
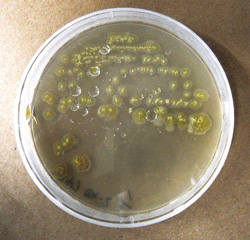

生物農薬生産へ、「薬を見つけ、設計図を理解し、新しいものを創り出す」
|
『植物に共生する微生物を利用した環境低負荷型生物農薬に関する研究』 <第20回(平成23年度)〜第21回(平成24年度)助成> 代表研究者 大阪大学 生物工学国際交流センター 准教授 木谷 茂さん |
|
|||||
微生物による薬創りの道筋をつける
| ----生物工学国際交流センターはどのような活動をしているのですか。 | ||
バイオテクノロジー分野でのアジアの先端研究拠点として、主に生物機能開発を目的とした教育・研究及び国際学術交流を行っています。例えば30年以上前から東南アジア諸国を中心とする留学生を受け入れ、1年プログラムのトレーニングをしていますが、その卒業生は400名を超え、それぞれの国の中枢機関で活躍しています。またタイに東南アジア共同研究拠点を置き、世界的に注目を集めている熱帯・亜熱帯地域の微生物や植物からの生物機能発見と利用に関する研究体制を強化しています。さらに国内の大学や研究機関とも連携し、文部科学省、ユネスコ、日本学術振興会の関連事業運営にも積極的に関わっています。メンバー全員熱心に、そして楽しんで研究に取り組み、国際色あふれるセンターは大変活気に満ちています。
|
| ----その中で、木谷さんが専門としている分野は。 |
| 分子微生物学が私の専門です。何をしているかと言えば「薬を見つける、設計図を理解する、新しいものを創り出す」となります。つまり、まず多様な環境の中から薬効性をもつ物質=生物活性物質を生産する微生物を見つけ出し、その生物活性物質の特性と、どのようにして生産しているかの現象を遺伝子レベルで解明します。その基礎的な研究成果を基に医薬、農薬等、有用な化合物としての実用化・産業化に貢献する技術を開発しています。簡単に言うなら、「微生物による薬創りのための道筋をつける」研究です。 本研究はその一環で、解明対象を植物内生放線菌に特化し、2007年、熱帯に属するタイでの植物サンプル採取を皮切りに取り組み始めたものです。 |
独自の分類法で機能の多様性を追究
| ----植物内生放線菌とはどういうものですか。 | ||
|
植物内生放線菌は、植物に共生する微生物であり、植物の細胞内に生息する細菌の一つです。放線菌は自然界に広く分布していますが、土壌中に最も多く生息しています。例えば、私たちの生活に恩恵を与えている抗生物質等の生物活性物質は、放線菌から抽出・実用化され、また植物への生物農薬として開発されてきました。そしてその殆どが土壌放線菌由来のものです。しかし弊害の多い化学農薬に代わる生物農薬としては、植物への定着性が悪いのが欠点で、期待した効果が得られていないのが現状です。 そうした中、15年ほど前から植物に共生する菌があり、その一部は植物病原菌に対する抵抗力を与え、宿主となる植物の生育に悪影響がない等々の報告が相次ぎました。が、その後、まだ一般に普及する生物農薬生産法は十分に確立されていません。そこで私たちは2011年、多様性に富む伊豆半島の植物を採取しての「薬を見つける、設計図を理解する、新しいものを創り出す」研究をスタートさせました。
|
| ----他の植物内生放線菌研究と違った独自的な面はどんなところにあるのでしょうか。 | |||||||
もちろんこの研究は他の大学や研究機関、農薬関係の企業等で取り組まれています。それは一般的には、まず植物の採取、植物から植物内生放線菌の分離、菌を培養しながら他の共在菌を除去しての純化、生物活性物質生産の有無及び生産性の確認、生物活性物質の精製と同定というプロセスで行われます。その最初のポイントが植物内生放線菌の分離です。それには従来からの土壌放線菌の分離のために考案された複数の分離法の中から、普通1つの方法が任意に選択され適用されています。私たちの研究は、今回は4つの、しかも様々なアレンジを加えた分類法を採用し、分離した植物内生放線菌の機能の多様性を追究した点に独自性があると言えます。
|
まずは全ての設計図を手に入れたい
| ----新しい生物農薬創りに向けて、これまでにどのようなことが見えてきましたか。 | ||
伊豆半島の植物からは2012年中に102種類の植物内生放線菌を分離することに成功しました。その結果、分離法によって多いもので34種類、少ないものでは19種類と、得られる数に差があり、同じ植物サンプルでも放線菌の形状が異なることがわかりました。その上で分離した放線菌を培養・純化し生物活性物質生産能を測定したところ、15菌株が立枯病菌、根腐病菌、枯草菌等に対する抗微生物活性、40菌株が抗真菌(いわゆるカビ)活性を示しました。さらには複数の植物内生放線菌を持ち、その生物活性が異なる植物もあることが明らかになりました。こうした成果をマトリクス化するのは大変な作業ですが、これらが判明したのは大きな進歩です。現在、具体的に抗立枯病菌活性を標的にした生物農薬に向け、各活性物質の精製・同定を進めています。
|
| ----今後の取り組みについてお聞かせください。 |
| これまでは、見つけた1種類の植物内放線菌には1種類の生物活性物質を生産する設計図しか描かれていないと思っていましたが、研究によってそれが数倍の設計図を持つ可能性を確信しました。その設計図をすべて理解し、何を作っているか、あるいは作っていなければ作らせるということを、遺伝子工学を駆使しての設計図改変、また植物病原菌に詳しい研究者とのネットワーク構築等を通じて推進し、化合物の実用化・産業化に向けた技術情報の提供に努めていきます。 放線菌には、欧米を筆頭に世界的な関心が高まり、土壌や植物だけでなく、海洋、大気中等に生息する放線菌に対する研究が広がっています。今、抗癌作用があると評価された海洋放線菌由来の化合物について、その亜種を独自に採取しての研究も進めています。これらで必ず有用な成果を出すことが、今回の助成に対してもお応えすることになると気合を入れて取り組んでいます。 (取材日 2013年4月23日 吹田市・大阪大学) |